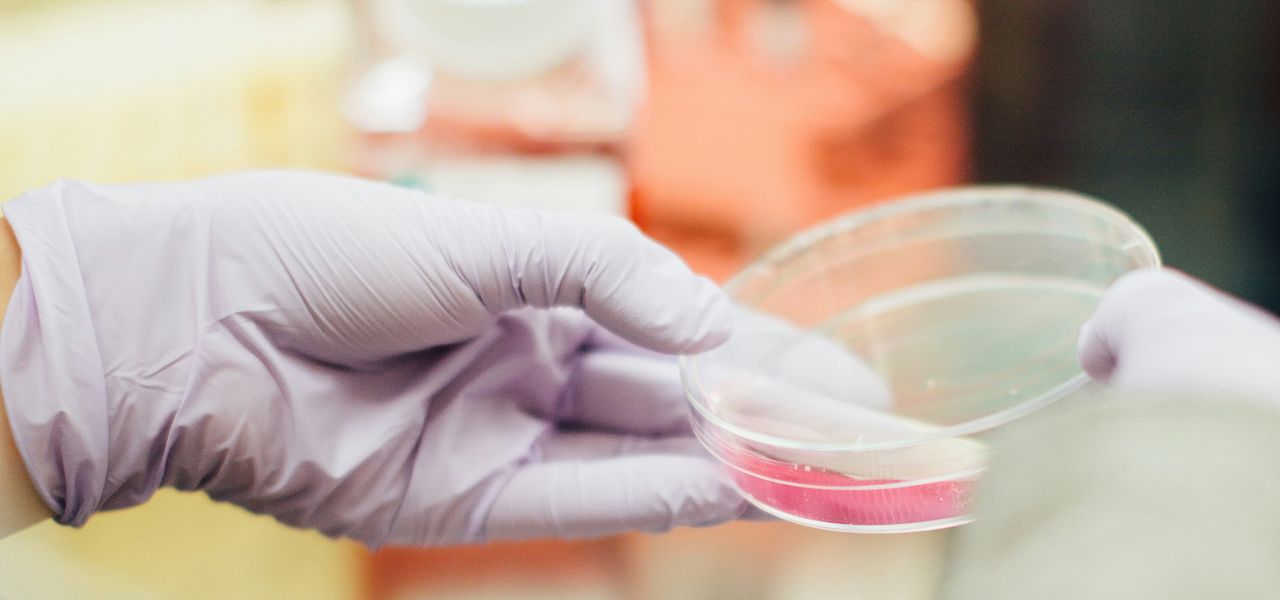
person holding round clear container

Clemondo utser ny valberedning inför 2026
Sammanfattning
Clemondo Group AB har utnämnt en ny valberedning inför årsstämman 2026, med syfte att säkerställa en kompetent och oberoende styrelse för bolagets framtida tillväxt.Clemondo Group AB, den nordiska kemtekniska koncernen med säte i Helsingborg, har meddelat att en ny valberedning har utsetts inför årsstämman 2026. Detta beslut togs i enlighet med riktlinjerna som fastställdes vid årsstämman den 22 maj 2025. Den nyutnämnda valberedningen består av Anders Månsson från LMK Forward AB som ordförande, samt Per August Bendt från P-A Bendt AB och Lottie Norén som ledamöter.
Valberedningens huvudsakliga uppgift är att säkerställa en kompetent, oberoende och väl sammansatt styrelse som kan stödja Clemondos fortsatta utveckling. Med tanke på den dynamiska marknaden för rengörings- och underhållsprodukter är det avgörande för Clemondo att ha en stark och strategiskt inriktad styrelse som kan navigera i framtida utmaningar och möjligheter.
För aktieägare som vill påverka styrelsens sammansättning finns möjlighet att lämna förslag och synpunkter via e-post till valberedningen. Detta öppnar upp för en inkluderande process där aktieägarnas röster kan bidra till bolagets framtida riktning.
Som en del av NASDAQ First North Growth Market har Clemondo visat en stark tillväxtpotential. Med den nya valberedningen på plats, och med en tydlig strategi för att stärka styrelsens sammansättning, är bolaget väl positionerat för att fortsätta sin positiva utveckling.
För investerare kan detta innebära en intressant möjlighet att följa bolagets framsteg och överväga en hold strategi. Med tanke på bolagets potential och den nya valberedningens kompetens kan det vara klokt att behålla aktier i väntan på framtida tillväxt och avkastning.


